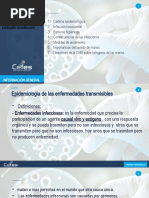

0% encontró este documento útil (0 votos)
97 vistas7 páginasCadena Epidemiologica
El documento describe la cadena epidemiológica del norovirus, causante de gastroenteritis, incluyendo su agente, reservorios, fuentes de infección, puertas de salida y entrada, así como modos y vías de transmisión. Se destaca que los humanos son los huéspedes más comunes y que la transmisión ocurre principalmente a través de la vía fecal-oral. Además, se menciona la presencia de portadores asintomáticos y la situación geográfica de los reservorios.
Cargado por
mariiaswiftieDerechos de autor
© © All Rights Reserved
Nos tomamos en serio los derechos de los contenidos. Si sospechas que se trata de tu contenido, reclámalo aquí.
Formatos disponibles
Descarga como PPTX, PDF, TXT o lee en línea desde Scribd
0% encontró este documento útil (0 votos)
97 vistas7 páginasCadena Epidemiologica
El documento describe la cadena epidemiológica del norovirus, causante de gastroenteritis, incluyendo su agente, reservorios, fuentes de infección, puertas de salida y entrada, así como modos y vías de transmisión. Se destaca que los humanos son los huéspedes más comunes y que la transmisión ocurre principalmente a través de la vía fecal-oral. Además, se menciona la presencia de portadores asintomáticos y la situación geográfica de los reservorios.
Cargado por
mariiaswiftieDerechos de autor
© © All Rights Reserved
Nos tomamos en serio los derechos de los contenidos. Si sospechas que se trata de tu contenido, reclámalo aquí.
Formatos disponibles
Descarga como PPTX, PDF, TXT o lee en línea desde Scribd